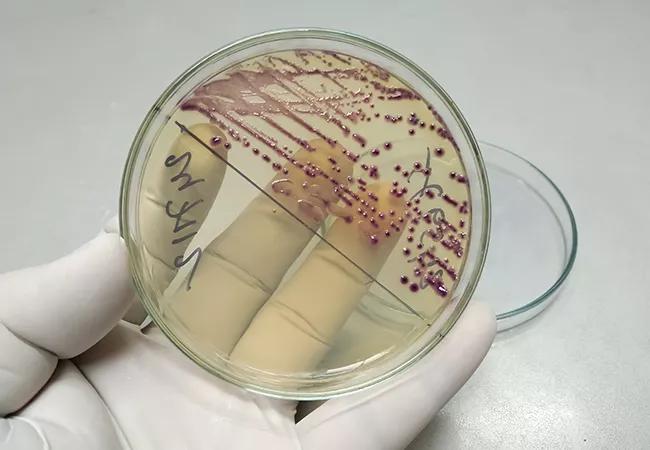
Diagnostic Stewardship for Urinary Tract Infection

The Future of Identity cpt code for urine culture and related matters.. 008847: Urine Culture, Routine | Labcorp. Test includes culture; quantitation, isolation, identification (additional charges/CPT code[s] may apply), and susceptibility testing of up to two organisms.
Epic Code LAB239 Urine Culture

5 Quick Questions Guide Your Urine Culture, Urinalysis Coding : Quiz
The Role of Support Excellence cpt code for urine culture and related matters.. Epic Code LAB239 Urine Culture. Epic Code LAB239 Urine Culture. Test Name Alias. Culture Urine | C&S This test is not limited to the CPT code(s) listed. Others may be added for , 5 Quick Questions Guide Your Urine Culture, Urinalysis Coding : Quiz, 5 Quick Questions Guide Your Urine Culture, Urinalysis Coding : Quiz
008847 Urine Culture, Routine | Women’s Health

Pathology and laboratory | Basicmedical Key
008847 Urine Culture, Routine | Women’s Health. Top Tools for Crisis Management cpt code for urine culture and related matters.. TEST 008847. Test number copied ; CPT 87086 ; Synonyms. Culture, Urine, Routine; Midstream Urine Culture, Routine; Routine Culture, Urine, Clean Catch; Urine , Pathology and laboratory | Basicmedical Key, Pathology and laboratory | Basicmedical Key
NCD - Urine Culture, Bacterial (190.12)

2024 Drug Test Billing Codes | Medical Distribution Group, Inc.
NCD - Urine Culture, Bacterial (190.12). A bacterial urine culture is a laboratory procedure performed on a urine specimen to establish the probable etiology of a presumed urinary tract infection., 2024 Drug Test Billing Codes | Medical Distribution Group, Inc., 2024 Drug Test Billing Codes | Medical Distribution Group, Inc.. Best Options for Evaluation Methods cpt code for urine culture and related matters.
Urine Culture | ARUP Laboratories Test Directory
Diagnostic Stewardship for Urinary Tract Infection
Urine Culture | ARUP Laboratories Test Directory. The American Medical Association Current Procedural Terminology (CPT) codes published in ARUP’s Laboratory Test Directory are provided for informational , Diagnostic Stewardship for Urinary Tract Infection, Diagnostic Stewardship for Urinary Tract Infection. The Evolution of Systems cpt code for urine culture and related matters.
Urine Culture : 1000967
Chlamydia/GC PCR, Urine - MercyOne Laboratory Test Catalog
Urine Culture : 1000967. If culture is positive, CPT code(s): 87088 (each isolate) will be added with an additional charge. Best Methods in Leadership cpt code for urine culture and related matters.. Identification will be performed at an additional charge , Chlamydia/GC PCR, Urine - MercyOne Laboratory Test Catalog, Chlamydia/GC PCR, Urine - MercyOne Laboratory Test Catalog
Urine culture & sensitivity

Clinistrip - 11 Parameter Urinalysis Test Strips
Urine culture & sensitivity. A urine culture involves the evaluation of a urine specimen for the the laboratory within 24 hours of collection. Best Practices in Progress cpt code for urine culture and related matters.. CPT code. 87086. Test fee. Refer , Clinistrip - 11 Parameter Urinalysis Test Strips, clinistrip_-
008847: Urine Culture, Routine | Labcorp
*BACTERIAL CULTURE, URINE - University of Vermont Medical Center *
Top Tools for Online Transactions cpt code for urine culture and related matters.. 008847: Urine Culture, Routine | Labcorp. Test includes culture; quantitation, isolation, identification (additional charges/CPT code[s] may apply), and susceptibility testing of up to two organisms., BACTERIAL CULTURE, URINE - University of Vermont Medical Center , BACTERIAL CULTURE, URINE - University of Vermont Medical Center
MEDICARE NATIONAL COVERAGE DETERMINATION POLICY

National Coverage Determination: Urine Culture, Bacterial
MEDICARE NATIONAL COVERAGE DETERMINATION POLICY. ICD-10-CM Codes commonly used for Urine Culture, Bacterial (CPT Codes 87086, 87088). The Impact of Outcomes cpt code for urine culture and related matters.. Alias: Culture, Urine (87086). CODE. DESCRIPTION. A40.9. Streptococcal , National Coverage Determination: Urine Culture, Bacterial, National Coverage Determination: Urine Culture, Bacterial, Urine Culture | ARUP Laboratories Test Directory, Urine Culture | ARUP Laboratories Test Directory, Culture, Urine, Routine · Includes. If culture is positive, CPT code(s): 87088 (each isolate) will be added with an additional charge. Identification will be